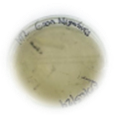

https://doi.org/10.35381/a.g.v7i13.4644
Aislamiento de bacterias hidrocarbonoclásticas en suelos contaminados con aceite lubricante en Puyo, Ecuador
Isolation of hydrocarbonoclastic bacteria in soils contaminated with lubricating oil in Puyo, Ecuador
Edison Roberto Suntasig-Negrete
Universidad Estatal Amazónica, Puyo, Pastaza
Ecuador
https://orcid.org/0000-0002-4908-6795
Joana Alexandra Moreno-López
Universidad Estatal Amazónica, Puyo, Pastaza
Ecuador
https://orcid.org/0009-0008-4427-670X
Karina María Elena Carrera-Sánchez
Universidad Estatal Amazónica, Puyo, Pastaza
Ecuador
https://orcid.org/0000-0003-1438-4466
Paul Marcelo Manobanda-Pinto
Universidad Estatal Amazónica, Puyo, Pastaza
Ecuador
https://orcid.org/0000-0003-0207-9229
Recibido: 05 de marzo 2025
Revisado: 13 de abril 2025
Aprobado: 29 de junio 2025
Publicado: 01 de julio 2025
RESUMEN
El estudio buscó identificar las bacterias con capacidad de degradar aceites y grasas en suelos contaminados de dos lubricadoras en Puyo, Pastaza. Se aislaron bacterias nativas de muestras de suelo de dos lubricadoras, para cada una de ellas se realizó cuatro réplicas y se caracterizaron morfológicamente mediante tinción de Gram. Las pruebas de catalasa resultaron positivas para las muestras de la lubricadora 1 y se detectó producción de ácido sulfhídrico en la prueba de fermentación. En contraste, las muestras de la lubricadora 2 resultaron negativas en la prueba de catalasa. Además, la cepa identificada como M2R1 correspondiente al punto de muestreo de la lubricadora 2 demostró capacidad de fermentar glucosa, lactosa y/o sacarosa. Las bacterias aisladas podrían pertenecer a los géneros Bacillus, Pseudomonas y Nocardia. Se recomiendan pruebas moleculares para identificar con precisión el género y especie de los aislados, para su potencial uso en la remediación de suelos contaminados.
Descriptores: Fermentación; morfotipo; cepa bacteriana; suelos contaminados; hidrocarburos contaminantes (Tesauro UNESCO).
ABSTRACT
The study sought to identify bacteria capable of degrading oils and fats in contaminated soil from two lubricators in Puyo, Pastaza. Native bacteria were isolated from soil samples from two lubricators, with four replicates performed for each, and characterized morphologically using Gram staining. The catalase tests were positive for the samples from lubricator 1, and hydrogen sulfide production was detected in the fermentation test. In contrast, the samples from lubricator 2 were negative in the catalase test. In addition, the strain identified as M2R1 corresponding to the sampling point of lubricator 2 demonstrated the ability to ferment glucose, lactose, and/or sucrose. The isolated bacteria could belong to the genera Bacillus, Pseudomonas, and Nocardia. Molecular tests are recommended to accurately identify the genus and species of the isolates for their potential use in the remediation of contaminated soils.
Descriptors: Fermentation;
morphotype; bacterial strain; contaminated soils; contaminating hydrocarbons;
biodegradation. (UNESCO Thesaurus) .
INTRODUCCIÓN
La actividad de las lubricadoras genera una gran problemática e impacto ambiental por el uso de aceites y grasas durante el cambio, mantenimiento, lavado de los motores de los automóviles. Estos productos contienen en su estructura hidrocarburos con metales pesados y representan un riesgo para los recursos naturales, principalmente para el suelo. Al depositarse en la superficie provocan su degradación y pérdida de sus propiedades originales (Mangieri et al., 2021). Como resultado provoca una alteración de la biota e indirectamente a la salud de la población que se encuentra en las zonas aledañas. La infiltración de los hidrocarburos hacia cursos de agua subterráneos causa afectación en la calidad del agua que puede utilizarse para consumo humano, además la exposición a estos compuestos puede resultar en efectos tóxicos en un largo plazo (Abasolo y Morante, 2020; Acuña et al., 2020; Castro et al., 2013).
El principal conflicto de los hidrocarburos o sus derivados cuando son vertidos al suelo son los daños que provoca en los diferentes procesos naturales, obstaculiza el intercambio de gases con la atmósfera, minimiza la actividad de la biota autóctona, pérdida de la fertilidad del suelo y por lo tanto también conlleva a una reducción de la cobertura vegetal (Acuña et al., 2020; Castro et al., 2013).
Otro de los desafíos principales es el poco control por parte de las autoridades, así como el uso de tecnologías obsoletas e ineficientes, lo cual ha desencadenado estos problemas ambientales como la contaminación de los recursos. A pesar de que existen normativas y ordenanzas a nivel local y regional para el control de las actividades de las lubricadoras, de cierto modo se ha logrado controlar exigiendo la implementación medidas para la gestión y disposición final de estos residuos (Morante, 2018; Flores et al., 2022). Estos residuos son provocados por el cambio de aceite de los vehículos, el lavado donde se utiliza agua, aceite y diésel, en las actividades de pulverizado o por algunos aditivos que contienen estos aceites (Padilla et al., 2022).
Además, las tecnologías de remediación en la actualidad resultan costosas y se debe tener amplio conocimiento de cómo aplicarlas, no todas resultan ser eficaces dependiendo de las condiciones del sitio. Por ello, el estudio de los microorganismos nativos del suelo resulta un tema de interés debido a que se puede obtener organismos autóctonos, estudiarlos, caracterizarlos y replicarlos para ser involucrados en procesos de remediación. El estudio de la microbiota del suelo y sus interacciones como potenciales biodegradadores en suelos contaminados con hidrocarburos de petróleo o sus derivados, permite identificar la capacidad de estos microorganismos para sobrevivir y adaptarse en suelos alterados en su composición y calidad. Lo anterior puede llegar a ser un gran aporte significativo para varios estudios existentes en procesos de recuperación de suelos según la investigación realizada en el cantón Quevedo (Abasolo y Morante, 2020; Hernández et al., 2020).
En este sentido, Montero (2015) realiza un estudio de las propiedades de los hongos para biodegradar hidrocarburos aislados a partir de suelos contaminados con petróleo en medios específicos. Para este tipo de microorganismos, obtenidos de muestras recolectadas en el cantón Lago Agrio, resulta que los hongos aislados demostraron un crecimiento significativo en presencia de petróleo crudo y diésel; así como propiedades degradadores de petróleo a escala laboratorio.
Las bacterias nativas del suelo son importantes en los procesos de remediación, estas tienen la capacidad para desarrollarse en ambientes contaminados y usar los hidrocarburos como medio para crecer y conseguir los nutrientes necesarios para sobrevivir en condiciones alteradas (Castillo et al., 2023; ). Este tipo de bacterias se las conoce como degradadoras de petróleo. Es importante mencionar que los hidrocarburos o sus derivados son altamente contaminantes por sus características. Estos poseen compuestos tales como nitrógeno, oxígeno, ciertos sulfuros y algunos compuestos metálicos (Guzmán y Montero, 2021). En este contexto se ha determinado que son las bacterias las que poseen un potencial para tolerar, adaptarse y ser capaces de utilizar algunos de estos compuestos mediante una serie de reacciones químicas (Rabelo Florez & Márquez Gómez, 2020).
Por esta razón, surge la necesidad de la presente investigación por la repercusión que las actividades de las lubricadoras generan en diversos entornos de Ecuador. En este contexto, se aborda el aislamiento y la caracterización de bacterias obtenidas de muestras de suelo contaminado con aceites lubricantes y grasas provenientes de las actividades de las lubricadoras (Castillo et al., 2020; Lozano-Mahecha & López-López, 2022). El objetivo de la investigación es identificar la capacidad de las bacterias para adaptarse a condiciones de contaminación, consumiendo hidrocarburos como fuente de alimento.
MÉTODO
El proyecto se llevó a cabo en la parroquia urbana Puyo, del cantón Pastaza, provincia de Pastaza, situada en una latitud de 1° 29’ 25” S y una longitud de 78° 00’ 08” O, con una extensión de 104 km². Pastaza tiene un clima tropical muy húmedo, con una temperatura media anual que oscila entre 24 y 26 °C, y una precipitación anual promedio de 3600 mm. El clima de Puyo presenta variaciones de temperaturas altas y precipitaciones frecuentes a lo largo del año, con una humedad relativa anual del 85.2%
Se identificaron dos sitios de muestreo en la zona urbana de Puyo:
· Lubricadora 1, en el sector del Barrio Las Palmas, y
· Lubricadora 2, en el paso lateral vía Puyo.
Estos sitios presentan una construcción mixta de cemento y piso de tierra, donde se observaron residuos de aceites y grasas, producto de sus actividades y por el manejo inadecuado de estos contaminantes. El suelo muestra manchas de color brillante y oscuro, además de un olor característico a aceites usados.
Para la recolección de muestras se empleó una adaptación de la metodología propuesta por del Rosario Lora Cahuas et al. (2022). Se llevó a cabo un muestreo aleatorio en dos puntos distintos de cada lubricadora estudiada, las cuales presenta características de disposición de aceites usados resultado de sus actividades. Se obtuvo una muestra compuesta representativa de 100 g por cada punto de muestreo, a una profundidad de 10 cm.
Se registró la ubicación de cada uno de los sitios de muestreo mediante georreferenciación y se determinó las condiciones de cada muestra recolectada. Las muestras fueron colocadas en bolsas tipo ziploc manteniendo las condiciones estériles. Se trasladaron al laboratorio de Microbiología de la Universidad Estatal Amazónica, se colocaron en refrigeración hasta realizar los análisis correspondientes, para garantizar las condiciones de la muestra se toma como referencia el procedimiento de De León (2021).
Para el aislamiento de bacterias de las muestras de suelo tomadas de los dos puntos de muestreo de la lubricadora 1 y lubricadora 2 respectivamente, se realizó diluciones seriadas para facilitar el conteo en colonias identificables. Posteriormente, se utilizó medio de cultivo Agar Nutriente para favorecer el crecimiento de los microorganismos objeto de estudio, que presenten características de adaptación a suelos contaminados con aceites usados.
Se utilizó la metodología adaptada de Montero (2015) como se detalla a continuación:
· Se tomó 1 g de la muestra de suelo homogenizada que corresponde a la Lubricadora 1, y de igual manera 1 g de la muestra de la Lubricadora 2.
· Se colocó 9 mL de agua destilada esterilizada en los tubos de ensayo con el fin de realizar las diluciones en serie de cada una de las muestras obtenidas.
· En el primer tubo de ensayo que contiene 9 mL de agua destilada estéril se colocó 1 g de la muestra 1, y de igual manera se repite el proceso para la muestra 2.
· Con la ayuda del agitador vórtex se agitaron las muestras para obtener una muestra homogénea, de las cuales se toma 1 mL y se coloca en el siguiente tubo de ensayo que contiene 9 mL de agua destilada estéril y se repite este paso sucesivamente hasta obtener una dilución de 10-6.
· Según la técnica establecida por Gómez et al. (2022), se tomó 1 mL del tubo que contiene la dilución 10-6 y se realizó la siembra en una caja Petri que contiene el medio de cultivo Agar Nutriente (AN) y se agita suavemente. El proceso se realizó en la cabina de flujo laminar para mantener las condiciones estériles y evitar contaminación.
· Se colocaron las cajas en la Incubadora a una temperatura de 36 °C, por un lapso de 48 horas, para determinar el crecimiento de bacterias, transcurrido este tiempo se realizó un conteo de las unidades formadoras de colonias que estuvieron presentes en la muestra.
Para la cuantificación de colonias bacterianas se aplica la fórmula 1:
![]() (1)
(1)
Donde:
UFC: Unidades formadoras de colonias
#colonias: número de colonias presentes en la placa
1 mL: cantidad en mL de la muestra sembrada
Inversa de la dilución: Factor de dilución de la muestra sembrada
Para este estudio se trabajó con dos muestras compuestas, cada una con cuatro réplicas para el punto lubricadora 1 y el punto 2 lubricadora 2.
A continuación, para la caracterización de bacterias, se aplicó la técnica de tinción de Gram y se observaron las características microscópicas de las cepas. La tinción se realizó según el procedimiento establecido por Casasola (2022):
· Previamente se preparó el área de trabajo para lo cual se requirió esterilizar el espacio de uso para evitar la contaminación de las muestras.
· Se tomó una muestra de la cepa bacteriana con un asa de cultivo y con la ayuda de un portaobjetos, previamente desinfectado, se colocó una gota de agua destilada y se realizó una extensión de la cepa bacteriana con movimientos suaves.
· La preparación se dejó secar, para lo cual se utilizó un mechero de alcohol pasando la muestra rápidamente asegurándose de que no esté expuesto por un tiempo prolongado lo cual podría alterar los resultados de la tinción.
· Se añadieron los reactivos de tinción, en el orden establecido en primer lugar el cristal violeta y se dejó reposar por 60 segundos, seguido se lavó con agua destilada contenida en una piseta con chorro suave, a la brevedad posible se coloca Lugol o solución de yodo por otros 60 segundos y se sigue el procedimiento antes descrito. Seguido se colocó alcohol acetona como decolorante y se lavó de igual manera con agua destilada; como paso final se adicionó el colorante safranina por 60 segundos y se procedió a lavar.
· Para la identificación en el microscopio se colocó en el portaobjetos una gota de aceite de inmersión. Primero se enfocó la muestra utilizando los objetivos de 40X, posteriormente se colocó en el lente de 100X para identificar las características que presentaron las bacterias en cuanto a su morfotipo después de haber realizado la tinción Gram.
Además, en cuanto a las características macroscópicas de las cepas bacterianas, se realizó una visualización directa en la caja Petri. Se utilizó un contador de colonias y se identificaron el color, la textura, la elevación y el margen de las colonias bacterianas.
Seguidamente, para identificar la temperatura óptima para el desarrollo de tres aislados bacterianos se sometieron a dos rangos de temperaturas para determinar si son psicrófilas (a 4 °C ± 2 °C) o termófilas (a 45 °C ± 2 °C) según Mora Delgado et al. (2019). Para lo cual se usó las bacterias aisladas del suelo previamente identificadas mediante tinción y se colocaron en la incubadora en el caso de temperaturas termófilas. Para las psicrófilas al tratarse de temperaturas bajas se optó por utilizar condiciones de refrigeración en los rangos establecidos para poder observar el crecimiento bacteriano por un lapso de 48 horas respectivamente. Se desarrollan las pruebas bioquímicas para la identificación de bacterias por las características que presente:
· Prueba de catalasa: La catalasa se encuentra presente en las bacterias aerobias y aerobias facultativas, para esta prueba se tomó con un sacabocado un disco de 5 mm de diámetro de las tres cepas bacterianas y se depositó en un portaobjetos al cual se le adicionó previamente una gota de agua oxigenada al 30%.
· Prueba en agar Triple azúcar hierro: Esta prueba se la realizó para determinar la capacidad que tienen las bacterias para fermentar ciertos hidratos de carbono tales como glucosa, lactosa y sacarosa y también la producción de ácido sulfhídrico.
El medio agar Triple azúcar hierro (TSI) contiene: extracto de carne bovina 3 g, extracto de levadura 3 g, digerido pancreático de caseína 15 g, peptona de proteosa N°3 5 g, dextrosa 1 g, lactosa 10 g, sacarosa 10 g, sulfato ferroso 0,2 g, cloruro sódico 5 g, tiosulfato sódico 0,3 g, agar 12 g, rojo fenol 0,024 g. Para la preparación de este medio específico se siguió el siguiente procedimiento:
· Se colocaron 5 mL de agar Triple azúcar hierro en 3 tubos de ensayo, cada uno correspondiente a una de las cepas en estudio. Los tubos se dejaron enfriar en una ligera inclinación para formar un pico de flauta.
· Luego con un sacabocado se extrajo un disco de 5 mm de la cepa en estudio, se introduce al fondo del tubo y se realiza una siembra en estría a lo largo de la superficie del medio.
Para la interpretación de los resultados se tomó como referencia lo establecido por Britanialab (2012) para lo cual se debe visualizar el cambio de color del medio TSI:
a) Superficie alcalina/profundidad ácida presenta (pico rojo/fondo amarillo): la bacteria estudiada tiene la capacidad para fermentar glucosa.
b) Superficie ácida/profundidad ácida presenta (pico amarillo/fondo amarillo): la cepa bacteriana objeto de estudio fermenta algunos de los tres hidratos de carbono glucosa, lactosa y/o sacarosa.
c) Superficie alcalina/Profundidad alcalina (pico rojo/fondo rojo): no fermenta ningún tipo de azúcar.
d) Si existe presencia de burbujas o a su vez se puede observar la ruptura del medio de cultivo se define como que la bacteria produce gas.
e) De igual manera si el medio de cultivo se torna de color oscuro o negruzco quiere decir la cepa bacteriana produce ácido sulfhídrico.
RESULTADOS
Aislamiento de bacterias a nivel de laboratorio de las muestras de suelo tomadas de dos lubricadoras de Puyo.
Después de 48 horas de incubación a 36 °C de las muestras se obtuvieron 8 aislados de bacterias procedentes del suelo de las dos lubricadoras objeto de estudio, localizadas en la zona urbana de la ciudad de Puyo. En las muestras se observó crecimiento bacteriano en los aislados, donde no se presentaron como colonias identificables; se visualizó una masa única que cubría la superficie del medio de cultivo. Debido al crecimiento abundante de bacterias se impidió realizar el conteo de unidades formadoras de colonias (UFC).
Caracterización morfológica de grupos bacterianos
Características macroscópicas
Los seis aislados codificados como (M1R1, M1R2, M1R3, M1R4, M2R1, M2R4) presentaron particularidades similares en cuanto a las características macroscópicas pigmentación ligeramente blanquecina, textura lisa, elevación plana y margen entero. Los dos aislados (M2R2 y M2R3) mostraron pigmentación levemente blanquecina, textura lisa, elevación convexa, margen lobulado.
Características microscópicas
Luego de realizar la tinción de Gram a las 8 cepas bacterianas aisladas, se logró determinar al grupo que pertenecen según la coloración obtenida. Seis de las cepas aisladas pertenecen al grupo de bacterias las Gram negativas (Gram –) y dos al grupo de bacterias Gram positivas (Gram +). Estos resultados se presentan en la Tabla 1.
Tabla 1.
Caracterización morfológica de las cepas bacterianas a 36 °C.
|
ID muestra |
Características macroscópicas |
Tinción Gram |
Dominio de Bacteria |
|
M1R1 |
|
|
Bacilos Gram - |
|
M1R2 |
|
|
Bacilos Gram - |
|
M1R3 |
|
|
Bacilos Gram - |
|
M1R4 |
|
|
Bacilos Gram - |
|
M2R1 |
|
|
Bacilos Gram - |
|
M2R2 |
|
|
Bacilos Gram + |
|
M2R3 |
|
|
Bacilos Gram + |
|
M2R4 |
|
|
Bacilos Gram + |
Elaboración: Los autores.
Montes (2005) señala que para la determinación morfológica de las bacterias se debe tomar en cuenta como responden frente a la coloración de Gram y que se puede distinguir los dos tipos de estructura de su pared celular con el uso de reactivos como el cristal violeta, uso de lugol como mordiente y la safranina como reactivo de contraste.
De los resultados obtenidos para determinar el Dominio de Bacteria se puede deducir que en su gran mayoría son bacterias Gram negativas (Gram–) por presentar una coloración fucsia o un tono rojizo al realizar la tinción, debido a que este tipo de bacterias poseen una pared celular con una fina capa de peptidoglicano. De igual manera, se pudo determinar que en la muestra de la lubricadora 2 existe una variación con respecto a los resultados de la muestra 1. Existe la presencia de bacterias Gram positivas (Gram+) presentando una coloración violeta o azulada al ponerse en contacto con los reactivos de tinción, a diferencia de las bacterias Gram negativas (Gram–). Según Casasola (2022) estas bacterias tienen una pared celular mucho más gruesa de peptidoglicano.
Bajo este contexto se describió que en la muestra 1 las cuatro réplicas presentaron características idénticas de coloración y forma. Por esta razón, se decidió trabajar solo con un aislado, identificado como M1R1, para las pruebas y ensayos posteriores. En contraste, en la muestra de la lubricadora 2, las cuatro réplicas mostraron que dos de las cepas eran bacilos Gram negativos (Gram -); se tomó la muestra M2R1 como referencia para los estudios. Además, en la misma muestra, dos cepas presentaron características Gram positivas (Gram +); se decidió trabajar con la muestra M2R2 para los siguientes ensayos.
Determinación de la temperatura óptima de crecimiento de las cepas bacterianas
De manera general, se observaron diferencias en el crecimiento micelial de los aislados bacterianos para las temperaturas en estudio.
La temperatura de 45 ± 2 °C fue la que se obtuvo el mayor crecimiento micelial bacteriano en el tiempo de evaluación en el que se identificó colonias plenamente diferenciables en la muestra M1R1 como colonias circulares de color ligeramente blanquecino, elevación convexa, margen entero, a diferencia de las muestras sometidas a 4 ± 2 °C en donde no se obtuvo crecimiento. Este resultado subraya la importancia de conocer los valores óptimos del desarrollo de los aislados para futuras investigaciones.
Este procedimiento es importante y es una de las claves para identificar a las bacterias en base a sus características de adaptación y soportar temperaturas superiores a las óptimas de crecimiento, según se detalla en la Tabla 2.
Se pudo identificar que las bacterias sometidas a temperaturas superiores a su temperatura óptima de crecimiento, en este caso incubadas a 45 ± 2°C, mostraron crecimiento en el medio de cultivo. Los resultados de la tinción indican la presencia de bacilos Gram negativos (Gram -) y Gram positivos (Gram +). La presencia de bacterias termófilas en suelos contaminados con aceites provenientes de actividades de lubricadoras es un ámbito no muy estudiado aún, la mayoría de las investigaciones generalmente indican que estos microorganismos crecen en condiciones de entre 15 y 40 °C; sin embargo, el ensayo realizado demuestra que estas bacterias tienen la capacidad de adaptarse a condiciones de temperatura relativamente altas.
Tabla 2.
Cepas bacterianas termófilas.
|
ID muestra |
Características macroscópicas |
T° |
Dominio de bacteria |
|
M1R1 |
|
45 ± 2 |
Bacilos Gram - |
|
M2R1
|
|
45 ± 2 |
Bacilos Gram - |
|
M2R2 |
|
45 ± 2 |
Bacilos Gram + |
Elaboración: Los autores.
En el caso de la muestra M1R1 al poder identificar colonias plenamente establecidas, también se logró realizar el conteo de las unidades formadoras de colonias obteniéndose valores de 1*107 UFC. De las otras cepas de la muestra 2 correspondiente a la codificación M2R1 y M2R2 no se puede realizar un conteo de colonias debido a que se presentan como una sola cepa en la caja Petri.
Es importante realizar este tipo de pruebas debido a que las bacterias tienen capacidad de soportar ambientes extremos, según Frioni (2005) quien detalla que la mayoría de microorganismos que habitan en ambientes naturales como en el suelo tienen un crecimiento óptimo en temperaturas de 30 - 40 °C, es decir ambientes mesófilos. Además menciona que los microorganismos termófilos en cuanto a su metabolismo son los más activos, cuando existe un incremento de 10 °C sobre la temperatura óptima de crecimiento aumenta la velocidad de las reacciones químicas realizadas por estos organismos, lo que provoca la desnaturalización de macromoléculas, así también proteínas y ácidos nucleicos.
Prueba de la catalasa
Para la prueba se trabajó con las tres cepas descritas como M1R1, M2R1 y M2R2 de las cuales la cepa codificada como M1R1 resultó positiva para esta prueba. Lo anterior se pudo verificar por la presencia de una efervescencia al colocar el disco de 5 mm tomado de la cepa en estudio y colocada en el peróxido de hidrógeno al 30%, esto debido a que existió una liberación de oxígeno dando como resultado positivo y negativo para las muestras M2R1 y M2R2, como se muestra en la Tabla 4.
Tabla 3.
Identificación de bacterias mediante pruebas bioquímicas.
|
ID muestra |
Prueba de catalasa |
Fermentación medio TSI |
|
|||
|
Glucosa |
Glucosa/ lactosa/ sacarosa |
Gas |
H2S |
Dominio de bacteria |
||
|
M1R1 |
+ |
|
|
|
+ |
Gram - |
|
M2R1 |
- |
- |
- |
- |
|
Gram - |
|
M2R2 |
- |
|
+ |
|
|
Gram + |
Elaboración: Los autores.
En contexto con los estudios realizados se puede determinar que las bacterias aisladas del suelo de la Lubricadora 1 M1R1 tienen la capacidad de oxidar los compuestos de los aceites y grasas presentes en la muestra, lo que es un indicativo de que estos microorganismos podrían ser de gran utilidad en los procesos de degradación de estos contaminantes.
Prueba en agar Triple azúcar hierro
Los resultados obtenidos de esta prueba para la cepa M1R1 se pudo observar el ennegrecimiento del medio de cultivo, este es un indicador de que esta bacteria produce ácido sulfhídrico. La muestra identificada como M2R1 presentó un pico y fondo rojo, interpretando este resultado se puede deducir que esta bacteria no fermenta ninguno de los tres hidratos de carbono.
Al contrario de la muestra M2R2 en la que se pudo observar que el medio de cultivo Agar TSI presentó un fondo y un pico amarillos lo que determina según la guía que esta cepa bacteriana puede fermentar dos o tres de los azúcares de los que consta la prueba como en el caso de la glucosa, lactosa y/o sacarosa, estos resultados coinciden con los presentados por Britanialab (2012).
DISCUSIÓN
Según Him et al. (2019) las pruebas de identificación de bacterias con potencial degradador de hidrocarburos realizada mediante tinción de Gram describe que todas las cepas aisladas presentaron iguales características en cuanto a su coloración, tornándose de color violeta y que además presentaban forma de bacilos. Es decir, las cepas bacterianas objeto de estudio son Gram positivas (Gram +) en la prueba de degradación de aceites, determinado sus características mediante el proceso de tinción. Estos resultados difieren de los obtenidos en el presente trabajo de investigación en donde se observó que únicamente dos de los aislados pertenecen al Dominio de los Gram positivos (Gram +).
Adicionalmente, Rabelo Florez & Márquez Gómez (2020) describen la presencia de bacterias Gram negativas (Gram -) destacando que en estos ambientes contaminados prevalecen este dominio con potencial para descomponer y degradar los derivados de petróleo. Este grupo de bacterias poseen en su membrana externa lipopolisacáridos que al entrar en contacto con los hidrocarburos que son de carácter lipídico aumentan su capacidad degradativa, coincidiendo con los hallazgos obtenidos que se identificó que las seis cepas bacterianas son bacilos Gram negativos (Gram -).
Por otra parte, de acuerdo con Caycedo et al. (2021) existen varios factores determinantes para la que las bacterias puedan desarrollarse, como es el caso de la temperatura. Las bacterias poseen la capacidad para adaptarse y desarrollarse en varios ambientes. Sin embargo, cada especie tiene un rango de temperatura en el cual se puede determinar que existe un crecimiento óptimo. Cuando hay un aumento en cuanto a la velocidad de crecimiento aunado al incremento de temperatura se da porque existe también un acrecentamiento de las diversas reacciones enzimáticas que realizan las bacterias. Al contrario cuando no existe crecimiento de los microorganismos cuando son sometidos a bajas temperaturas se da porque la velocidad de reacción de las enzimas disminuye y existe una transformación del estado en el que se encuentran los lípidos. En concordancia con los resultados de este proyecto se determinó que el mejor crecimiento se obtuvo sometiendo a las cepas bacterianas a 45 ± 2 °C.
Además, según el procedimiento de Cercenado y Cantón (2010) describen los requisitos de crecimiento de los microorganismos en base las condiciones de temperatura y determinan que la mayoría de las bacterias son mesofílicas, es decir que pueden desarrollarse en un rango de temperatura entre 15 a 40 °C, diferenciando de las respuestas obtenidas en este trabajo.
En el caso de la prueba de catalasa, según Romero et al. (2017) la prueba realizada a las cepas bacterianas previamente identificadas demostró que se puede realizar para la identificación de bacterias. Además, Him et al. (2019) en la prueba de catalasa realizadas para la identificación de cepas bacterianas describe que los resultados obtenidos de esta prueba fueron positivos en todos los aislamientos. Esta característica es crucial debido a que está relacionado con la capacidad de oxidación de algunos compuestos derivados de petróleo debido al contenido de peroxidasas. Lo anterior descrito difiere con los resultados obtenidos en este trabajo ya que únicamente la muestra que corresponde a M1R1 dio positiva para esta prueba.
Según la caracterización de cepas bacterianas realizadas por Morante et al. (2018), describe que de las bacterias aisladas en suelos contaminados con presencia de hidrocarburos 15 de los aislados a los que se realizó pruebas bioquímicas resultaron positivos para catalasa y las mismas también presentaron características Gram negativas (Gram -).
Por último, el estudio realizado para el aislamiento e identificación de Bacillus thurigiensis realizado por Romero et al. (2017), muestran que esta es una bacteria que sometida a esta prueba en agar TSI, tiene la capacidad de fermentar glucosa. Por tanto, se demuestra por la formación de un pico y fondo rojo y amarillo respectivamente, como resultado positivo a esta prueba, lo que demuestra que existe la presencia de estos microorganismos. Estos resultados son similares a los obtenidos en esta investigación en el aislado M2R2.
CONCLUSIONES
De acuerdo con la caracterización morfológica realizada a las cepas bacterianas se pudo identificar la presencia de 6 aislados bacterianos Gram negativos (Gram -), y dos de los aislados corresponden al Dominio de bacteria Gram positivo (Gram +), en forma de bacilos. De igual manera se logró definir que estas bacterias tienen la capacidad de desarrollarse en condiciones termófilas a 45 ± 2 °C. De las pruebas bioquímicas realizadas se demostró que uno de los aislados resultó positivo para la prueba de catalasa y positivo para fermentación de glucosa, lactosa y/o sacarosa.
A partir del análisis de los resultados de los ensayos de laboratorio, se puede sugerir que las bacterias aisladas podrían pertenecer a los géneros Bacillus, Pseudomonas y Nocardia, esto en contraste con los datos obtenidos de la identificación de los morfotipos y pruebas bioquímicas realizadas.
La presencia de estos microorganismos en el suelo en condiciones específicas indica su capacidad de adaptación y supervivencia en estos entornos. Su eventual uso a gran escala podría representar un avance en la mitigación de la contaminación ambiental y la preservación de las características del suelo, especialmente considerando las actividades generadas por las lubricadoras.
No monetario.
AGRADECIMIENTO
A todos los actores sociales involucrados en el desarrollo de la investigación.
REFERENCIAS CONSULTADAS
Abasolo, F., y Morante, L. (2020). Bacterias degradadoras de hidrocarburos a partir de suelos contaminados con hidrocarburos. Biblioteca Colloquium. https://n9.cl/fobhs
Acuña, A., Cambarieri, L., y Pucci, G. (2020). Impacto sobre la biota microbiana del suelo por contaminantes provenientes de estaciones de servicio. Revista Peruana de biología 27(3), 417-422. https://dx.doi.org/10.15381/rpb.v27i3.17387
Britanialab. (2012). T.S.I. Agar (Triple Sugar Iron Agar). (REF-B0213405-B0213406). Laboratorios Britania S. A. https://n9.cl/9e405
Caycedo, L., Corrales, L., y Trujillo, D. (2021). Las bacterias, su nutrición y crecimiento: una mirada desde la química. Revista Nova, 19(36). https://doi.org/10.22490/24629448.5293
Casasola, M. (2022). La importancia de realizar una correcta tinción de Gram en la identificación bacteriana. Rev. Colegio de Microb. Quím. Clín. de Costa Rica, 27(2). https://n9.cl/xn8r22
Castillo, R., More, F., Cornejo, M., Fernández, J., y Mialhe, E. (2020). Aislamiento de bacterias con potencial biorremediador y análisis de comunidades bacterianas de zona impactada por derrame de petróleo en Condorcanqui – Amazonas – Perú. Revista de Investigaciones Altoandinas, 22(3), 215-225. https://dx.doi.org/10.18271/ria.2020.656
Castillo, R., Treviño, J., López, J., Osorio, E., Poot, W., y Estrada, B. (2023). Importancia de las bacterias nativas de ambientes acuáticos afectados por derrames de petróleo. Investigación y Ciencia de la Universidad Autónoma de Aguascalientes, 31(88). https://n9.cl/lyc43x
Castro, Y., Castro, B., De la Garza, F., Rivera, H., y Ortiz, Y. (2013). Variación de las Poblaciones Microbianas del Suelo por la Adición de Hidrocarburos. TERRA Latinoamérica, 31(3), 221-230. https://n9.cl/vaoe5
Cedeño, A., y Canchignia, H., (2022). Empleo de bacterias como alternativa de biorremediación en suelos contaminados con Mercurio (Hg), Zinc (Zn), Aluminio (Al) y Cobre (Cu) Con empleo de bacterias. Editorial Universidad Técnica Estatal de Quevedo.
Cercenado, E., & Cantón, R. (2010). Métodos de identificación bacteriana en el laboratorio de microbiología. Seimc. https://n9.cl/nan9zn
De León, M. (2021). Identificación de los principales mecanismos de adaptación de bacterias anaerobias presentes en suelos contaminados por actividades mineras. [Trabajo de maestría, Universidad Autónoma de Aguascalientes. Repositorio Bibliográfico. http://hdl.handle.net/11317/2144
Flores, L., Briseño, E., Loeza, P., y Jiménez, R. (2022). Antifungal activity and plant growth promotion characteristics of hydrocarbon degrading Pseudomonas aeruginosa and Enterobacter sp. Isolated from polluted soil. Acta Biologica Colombiana, 27(3), 366-376. https://doi.org/10.15446/abc.v27n3.92758
Frioni, L. (2005). Microbiología Básica, ambiental y agrícola. Universidad de la República. https://n9.cl/6y8pv
Gómez, Z., Madariaga, A., Vázquez, A., Islas, M., Aquino, E., Prieto, J., y Delgado, C. (2022). Aislamiento de consorcio bacteriano localmente adaptado a suelo con antecedentes de acetoclor. South Florida Journal of Development, 3(2), 2699-2707. https://doi.org/10.46932/sfjdv3n2-088
Guzmán, D., y Montero, J. (2021). Interacción de bacterias y plantas en la fijación del nitrógeno. Revista de Investigación e Innovación Agropecuaria y de Recursos Naturales, 8(2). https://doi.org/10.53287/uyxf4027gf99e
Hernández, I., Guitián, D., y González, V. (2020). Toxicidad de suelos contaminados con petróleo pesado sobre plántulas de la palma moriche Mauritia flexuosa L. f. In Bioagro, 32(2), 117-122. https://n9.cl/xtt861
Him, J., Ábrego, I., y Aldrete, M. (2019). Identificación y capacidad degradora de bacterias aisladas de suelos contaminados con hidrocarburos de desechos, panamá. Revista Colegiada de Ciencia, 1(1). https://n9.cl/vwqyc
Lozano-Mahecha, R. A., & López-López, K. (2022). Aislamiento y caracterización de bacterias endémicas colombianas con capacidad de degradar tolueno. Revista Colombiana de Biotecnología, 24(1), 6-18. https://doi.org/10.15446/rev.colomb.biote.v24n1.98613
del Rosario Lora Cahuas, C. E., Otiniano García, N. M. E., & Robles Castillo, H. M. (2021). Degradation of lubricating oil by Pseudomonas aeruginosa. REBIOL, 41(2), 213-220. https://doi.org/10.17268/rebiol.2021.41.02.07
Mangieri, N., Guevara, D., Echavarria, G., Bertona, E., Catello, L., Benchetrit, G., y De Paulis., A. (2021). Nocardiosis esporotricoide por Nocardia brasiliensis. Revista Argentina de Microbiología, 53(1), 43-47. https://doi.org/10.1016/j.ram.2020.06.007
Montero, M. (2015). Estudio in vitro de las propiedades biodegradadoras de hidrocarburos, por parte de hongos aislados de suelos contaminados por petróleo. [Trabajo de grado, Universidad Estatal Amazónica]. Repositorio Dspace. https://n9.cl/nlu74
Montes, M. (2005). Estudio taxonómico polifásico de bacterias procedentes de ambientes antártidos: descripción de cuatro nuevas especies. [Tesis Doctoral, Universitat de Barcelona]. Dipòsit Digital. https://hdl.handle.net/2445/42390
Morante, L., Canchignia, H.,Morante, J., Romero, R., Cedeño, A., y Abasolo, F. (2018). Bacterias con potencialidades para la degradación de hidrocarburos en suelos contaminados de Quevedo, Ecuador. Revista Cubana de Ciencias Biológicas, 6(3), 1-8. https://n9.cl/xjnia1
Mora Delgado, J, Silva Parra, A y Escobar Escobar, N. (2019). Bioindicadores en suelos y abonos orgánicos. Sello Editorial Universidad del Tolima. https://n9.cl/q9j5w
Rabelo Florez, R. A., & Márquez Gómez, M. A. (2020). Bacterias Gram negativas biodegradadoras de hidrocarburos. Revista De Ciencias, 24(2), e9935. https://doi.org/10.25100/rc.v24i2.9935
Romero, J., Canales, E., Meneses, P., Herbozo, S., (2017). Aislamiento e identificación de Bacillus Thuringiensis en cultivos de plátano,para la producción de bioinsecticidas. Big Bang Faustiniano, 6(1), 15-18. https://n9.cl/34uhe
©2025 por los autores. Este artículo es de acceso abierto y distribuido según los términos y condiciones de la licencia Creative Commons Atribución-NoComercial-CompartirIgual 4.0 Internacional (CC BY-NC-SA 4.0) (https://creativecommons.org/licenses/by-nc-sa/4.0/).